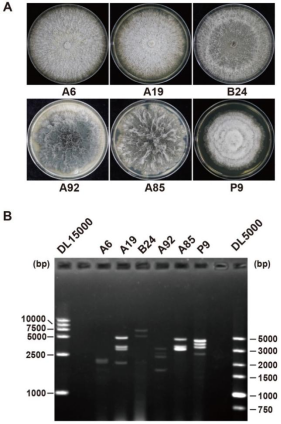

近日,中国热科院南亚所园艺产品保鲜与加工研究室在芒果病原真菌的病毒多样性研究方面取得重要研究进展。
芒果是重要热带经济作物,生长发育过程中受到多种病原真菌的危害,严重影响芒果生长和果实的采后保鲜。为探索芒果病原真菌携带的病毒,本研究从罹患叶斑病的芒果叶片中分离出300余株真菌菌株,筛选出6株携带双链rna(dsrna)的菌株,并基于病毒组学技术从中鉴定出10种新型病毒。这些病毒分别属于8个分类单元,包括alternaviridae, chrysoviridae, partitiviridae, polymycoviridae, orthototiviridae, deltaflexiviridae, narnaviridae, bunyaviricetes。其中,有七种病毒基因组由多个rna片段组成。通过对病毒末端序列进行比对发现,病毒各rna片段的末端存在保守序列,是病毒进行复制的结构基础。同时,这些病毒中存在多个未知功能的开放阅读框,如ppav1的片段2、4,brpmv1的片段4,npcv2和pmcv1的片段3、4等,这些片段均编码没有保守结构域的假定蛋白。本研究发现的新病毒为认识病毒多样性提供了基础。

图1. 携带病毒的真菌菌落形态和病毒dsrna鉴定
该研究成果以“discovery of novel mycoviruses from fungi associated with mango leaf spots”为题发表于学术期刊《frontiers in microbiology》。中国热带农业科学院南亚热带作物研究所王其华博士和华中农业大学陈梦仪为论文共同第一作者,王其华为通讯作者。项目研究得到了中央级公益性科研院所基本科研业务费专项(no.1630062024006和no.1630062024016)的支持。
全文链接:
近日,中国热科院南亚所园艺产品保鲜与加工研究室在芒果病原真菌的病毒多样性研究方面取得重要研究进展。
芒果是重要热带经济作物,生长发育过程中受到多种病原真菌的危害,严重影响芒果生长和果实的采后保鲜。为探索芒果病原真菌携带的病毒,本研究从罹患叶斑病的芒果叶片中分离出300余株真菌菌株,筛选出6株携带双链rna(dsrna)的菌株,并基于病毒组学技术从中鉴定出10种新型病毒。这些病毒分别属于8个分类单元,包括alternaviridae, chrysoviridae, partitiviridae, polymycoviridae, orthototiviridae, deltaflexiviridae, narnaviridae, bunyaviricetes。其中,有七种病毒基因组由多个rna片段组成。通过对病毒末端序列进行比对发现,病毒各rna片段的末端存在保守序列,是病毒进行复制的结构基础。同时,这些病毒中存在多个未知功能的开放阅读框,如ppav1的片段2、4,brpmv1的片段4,npcv2和pmcv1的片段3、4等,这些片段均编码没有保守结构域的假定蛋白。本研究发现的新病毒为认识病毒多样性提供了基础。
图1. 携带病毒的真菌菌落形态和病毒dsrna鉴定
该研究成果以“discovery of novel mycoviruses from fungi associated with mango leaf spots”为题发表于学术期刊《frontiers in microbiology》。中国热带农业科学院南亚热带作物研究所王其华博士和华中农业大学陈梦仪为论文共同第一作者,王其华为通讯作者。项目研究得到了中央级公益性科研院所基本科研业务费专项(no.1630062024006和no.1630062024016)的支持。
全文链接: